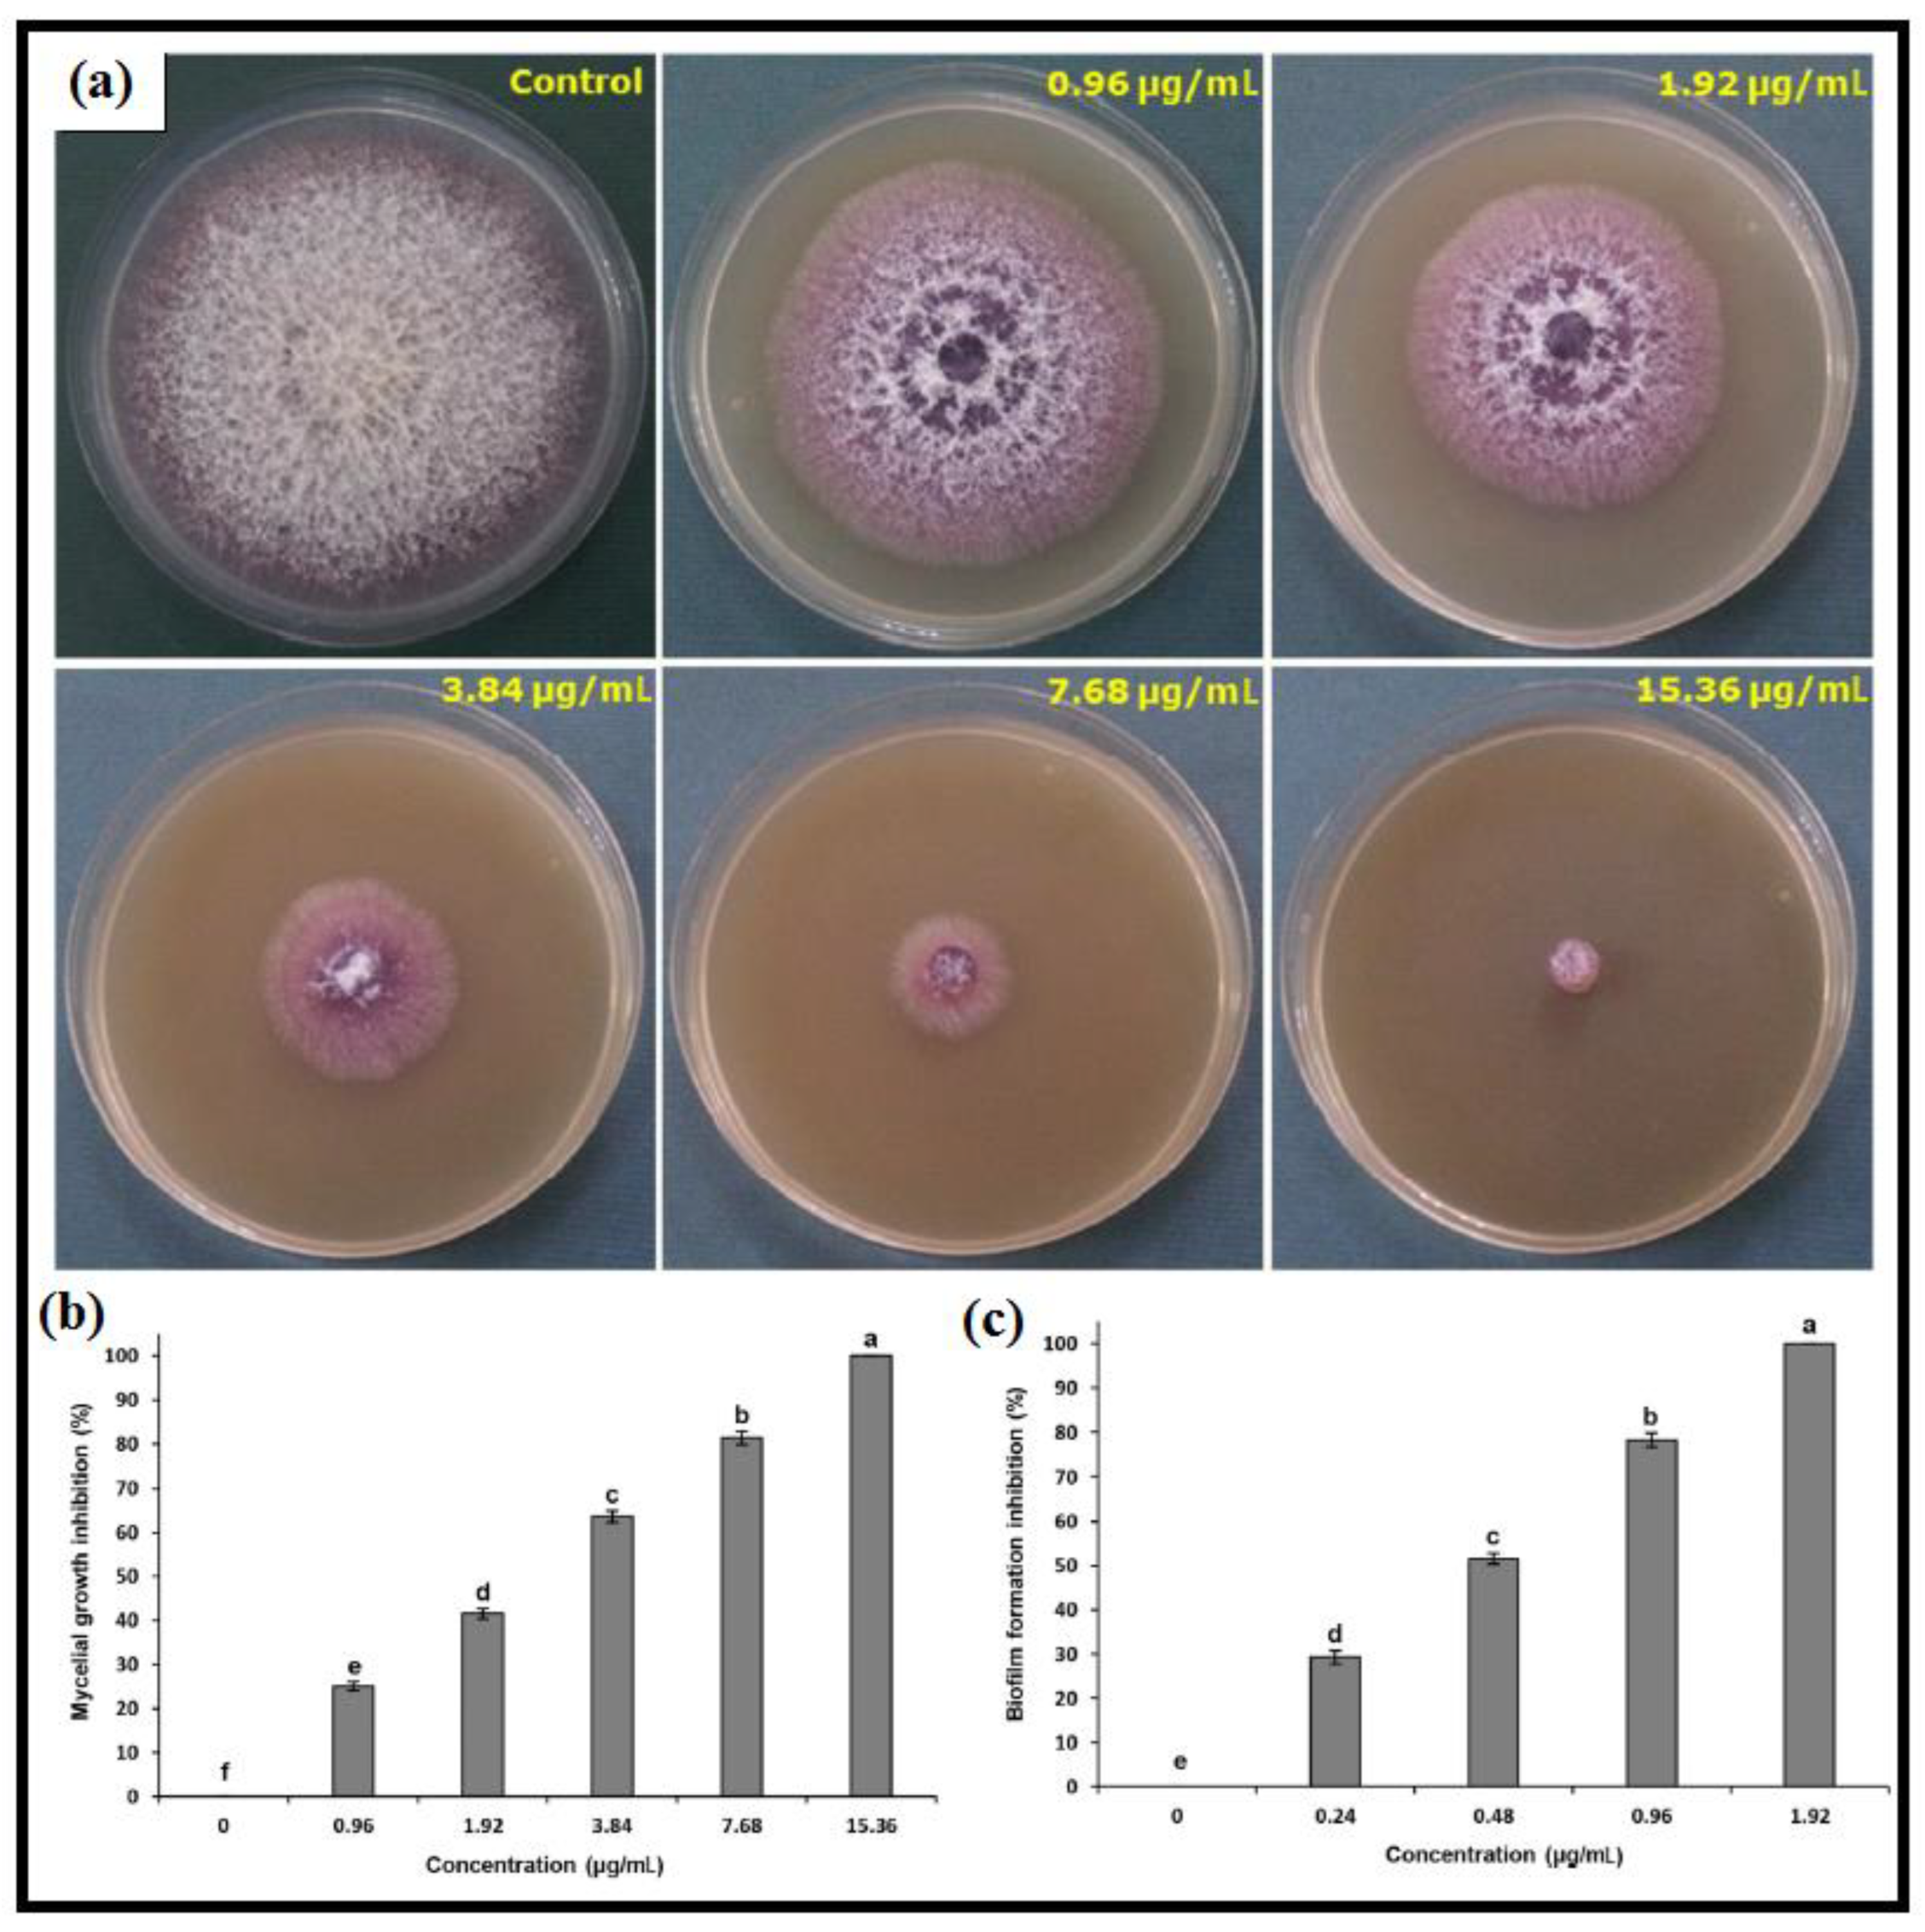
Catalysts 13 00642 g009 Catalysts 13 00642 g009

Green Synthesis of Magnesium Oxide Nanoparticles and Nanocomposites for Photocatalytic Antimicrobial, Antibiofilm and Antifungal Applications
Abstract
1. Introduction
2. Bio-Templates-Mediated Synthesis Strategies
2.1. Plant Extracts
2.2. Bacterial Extracts

| No. | Biological Source | Magnesium Source | Particle Size (nm) | Morphology | Ref. |
|---|---|---|---|---|---|
| 1 | Lactobacillus plantarum Lactobacillus | Magnesium nitrate | <30 | Spherical and oval | [94] |
| 2 | Penicillium chrysogenum | Magnesium nitrate | 7−40 | Spherical | [96] |
| 3 | Sargassum wightii | Magnesium chloride | 68.6 | Cubic | [97] |
| 4 | Streptomyces sp. | Magnesium nitrate | 25 | Spherical | [98] |
| 5 | Acinetobacter johnsonii | Magnesium nitrate | 18−45 | Spherical | [99] |
| 6 | Trichoderma aureoviride | Magnesium nitrate | 13.7 | Spherical | [100] |
| 7 | Aspergillus carbonarious D-1 | Magnesium nitrate | 20–86 | Spherical | [101] |
| 8 | Rhizopus oryaze | Magnesium nitrate | 20.38 ± 9.9 | Spherical | [102] |
| 9 | Burkholderia rinojensis | Magnesium nitrate | 26.70 | Roughly spherical granular | [103] |
2.3. Fungi Extracts
2.4. Algae Extracts
3. Applications of Photocatalytic Treatment
3.1. Antimicrobial Activity
3.2. Antibiofilm Activity
3.3. Antifungal Activity
4. MgO Nanocomposite
5. Conclusions and Prospects
Author Contributions
Funding
Data Availability Statement
Conflicts of Interest
References
- Baig, N.; Kammakakam, I.; Falath, W. Nanomaterials: A review of synthesis methods, properties, recent progress, and challenges. Mater. Adv. 2021, 2, 1821–1871. [Google Scholar] [CrossRef]
- Njuguna, J.; Ansari, F.; Sachse, S.; Rodriguez, V.M.; Siqqique, S.; Zhu, H. Nanomaterials, nanofillers, and nanocomposites: Types and properties. In Health and Environmental Safety of Nanomaterials; Elsevier: Amsterdam, The Netherlands, 2021; pp. 3–37. [Google Scholar]
- Cohen-Tanugi, D.; Grossman, J.C. Mechanical Strength of Nanoporous Graphene as a Desalination Membrane. Nano Lett. 2014, 14, 6171–6178. [Google Scholar] [CrossRef] [PubMed]
- Xu Du, I.S.; Barker, A.; Andrei, E.Y. Approaching ballistic transport in suspended grapheme. Nat. Nanotechnol. 2008, 3, 491–495. [Google Scholar] [CrossRef] [PubMed]
- Fan, Y.; Liu, S.; Yi, Y.; Rong, H.; Zhang, J. Catalytic Nanomaterials toward Atomic Levels for Biomedical Applications: From Metal Clusters to Single-Atom Catalysts. ACS Nano 2021, 15, 2005–2037. [Google Scholar] [CrossRef] [PubMed]
- Akhavan, O. Lasting antibacterial activities of Ag–TiO2/Ag/a-TiO2 nanocomposite thin film photocatalysts under solar light irradiation. J. Colloid Interface Sci. 2009, 336, 117–124. [Google Scholar] [CrossRef]
- Chouke, P.B.; Shrirame, T.; Potbhare, A.K.; Mondal, A.; Chaudhary, A.R.; Mondal, S.; Thakare, S.R.; Nepovimova, E.; Valis, M.; Kuca, K.; et al. Bioinspired metal/metal oxide nanoparticles: A road map to potential applications. Mater. Today Adv. 2022, 16. [Google Scholar] [CrossRef]
- Rahimnejad, M.; Rasouli, F.; Jahangiri, S.; Ahmadi, S.; Rabiee, N.; Farani, M.R.; Akhavan, O.; Asadnia, M.; Fatahi, Y.; Hong, S.; et al. Engineered Biomimetic Membranes for Organ-on-a-Chip. ACS Biomater. Sci. Eng. 2022, 8, 5038–5059. [Google Scholar] [CrossRef]
- Chen, W.; Li, S.; Wang, J.; Sun, K.; Si, Y. Metal and metal-oxide nanozymes: Bioenzymatic characteristics, catalytic mechanism, and eco-environmental applications. Nanoscale 2019, 11, 15783–15793. [Google Scholar] [CrossRef]
- Akhavan, O.; Ghaderi, E. Flash photo stimulation of human neural stem cells on graphene/TiO2 heterojunction for differentiation into neurons. Nanoscale 2013, 5, 10316–10326. [Google Scholar] [CrossRef]
- Rabiee, N.; Ahmadi, S.; Akhavan, O.; Luque, R. Silver and Gold Nanoparticles for Antimicrobial Purposes against Multi-Drug Resistance Bacteria. Materials 2022, 15, 1799. [Google Scholar] [CrossRef]
- Akhavan, O.; Ghaderi, E. Photocatalytic Reduction of Graphene Oxide Nanosheets on TiO2 Thin Film for Photoinactivation of Bacteria in Solar Light Irradiation. J. Phys. Chem. C 2009, 113, 20214–20220. [Google Scholar] [CrossRef]
- Akhavan, O.; Choobtashani, M.; Ghaderi, E. Protein Degradation and RNA Efflux of Viruses Photocatalyzed by Graphene–Tungsten Oxide Composite Under Visible Light Irradiation. J. Phys. Chem. C 2012, 116, 9653–9659. [Google Scholar] [CrossRef]
- Ramanujam, K.; Sundrarajan, M. Antibacterial effects of biosynthesized MgO nanoparticles using ethanolic fruit extract of Emblica officinalis. J. Photochem. Photobiol. B: Biol. 2014, 141, 296–300. [Google Scholar] [CrossRef]
- Bhoi, H.; Tiwari, S.; Lal, G.; Jani, K.K.; Modi, S.K.; Seal, P.; Saharan, V.; Modi, K.B.; Borah, J.; Punia, K.; et al. Green synthesis and characterization of Mg0.93Na0.07O nanoparticles for antimicrobial activity, cytotoxicity and magnetic hyperthermia. Ceram. Int. 2022, 48, 28355–28373. [Google Scholar] [CrossRef]
- Khan, M.I.; Akhtar, M.N.; Ashraf, N.; Najeeb, J.; Munir, H.; Awan, T.I.; Tahir, M.B.; Kabli, M.R. Green synthesis of magnesium oxide nanoparticles using Dalbergia sissoo extract for photocatalytic activity and antibacterial efficacy. Appl. Nanosci. 2020, 10, 2351–2364. [Google Scholar] [CrossRef]
- Amaral, L.; Oliveira, I.; Salomão, R.; Frollini, E.; Pandolfelli, V. Temperature and common-ion effect on magnesium oxide (MgO) hydration. Ceram. Int. 2010, 36, 1047–1054. [Google Scholar] [CrossRef]
- Hornak, J.; Trnka, P.; Kadlec, P.; Michal, O.; Mentlík, V.; Šutta, P.; Csányi, G.M.; Tamus, Z. Magnesium Oxide Nanoparticles: Dielectric Properties, Surface Functionalization and Improvement of Epoxy-Based Composites Insulating Properties. Nanomaterials 2018, 8, 381. [Google Scholar] [CrossRef]
- Wang, B.; Xiong, X.; Ren, H.; Huang, Z. Preparation of MgO nanocrystals and catalytic mechanism on phenol ozonation. RSC Adv. 2017, 7, 43464–43473. [Google Scholar] [CrossRef]
- Zhao, L.C.; Cui, C.X.; Liu, S.J.; Qi, Y.M. Influence of In Situ MgO Coating on Corrosion Resistance of Pure Magnesium in Normal Saline. Adv. Mater. Res. 2009, 79-82, 1039–1042. [Google Scholar] [CrossRef]
- Shen, Y.; He, L.; Yang, Z.; Xiong, Y. Corrosion Behavior of Different Coatings Prepared on the Surface of AZ80 Magnesium Alloy in Simulated Body Fluid. J. Mater. Eng. Perform. 2020, 29, 1609–1621. [Google Scholar] [CrossRef]
- Pilarska, A.A.; Klapiszewski, Ł.; Jesionowski, T. Recent development in the synthesis, modification and application of Mg(OH)2 and MgO: A review. Powder Technol. 2017, 319, 373–407. [Google Scholar] [CrossRef]
- Ding, Y.; Zhang, G.; Wu, H.; Hai, B.; Wang, L.; Qian, Y. Nanoscale Magnesium Hydroxide and Magnesium Oxide Powders: Control over Size, Shape, and Structure via Hydrothermal Synthesis. Chem. Mater. 2001, 13, 435–440. [Google Scholar] [CrossRef]
- Sain, M.; Park, S.; Suhara, F.; Law, S. Flame retardant and mechanical properties of natural fibre–PP composites containing magnesium hydroxide. Polym. Degrad. Stab. 2004, 83, 363–367. [Google Scholar] [CrossRef]
- Kipcak, A.S.; Acarali, N.B.; Derun, E.M.; Tugrul, N.; Piskin, S. Effect of Magnesium Borates on the Fire-Retarding Properties of Zinc Borates. J. Chem. 2014, 2014, 512164 . [Google Scholar] [CrossRef]
- Tang, H.; Zhou, X.-B.; Liu, X.-L. Effect of Magnesium Hydroxide on the Flame Retardant Properties of Unsaturated Polyester Resin. Procedia Eng. 2013, 52, 336–341. [Google Scholar] [CrossRef]
- Itatani, K.; Tsujimoto, T.; Kishimoto, A. Thermal and optical properties of transparent magnesium oxide ceramics fabricated by post hot-isostatic pressing. J. Eur. Ceram. Soc. 2006, 26, 639–645. [Google Scholar] [CrossRef]
- Khalil, K.D.; Bashal, A.H.; Khalafalla, M.; Zaki, A.A. Synthesis, structural, dielectric and optical properties of chitosan-MgO nanocomposite. J. Taibah Univ. Sci. 2020, 14, 975–983. [Google Scholar] [CrossRef]
- Abinaya, S.; Kavitha, H.P.; Prakash, M.; Muthukrishnaraj, A. Green synthesis of magnesium oxide nanoparticles and its applications: A review. Sustain. Chem. Pharm. 2021, 19, 100368. [Google Scholar] [CrossRef]
- Panchal, P.; Paul, D.R.; Gautam, S.; Meena, P.; Nehra, S.; Maken, S.; Sharma, A. Photocatalytic and antibacterial activities of green synthesized Ag doped MgO nanocomposites towards environmental sustainability. Chemosphere 2022, 297, 134182. [Google Scholar] [CrossRef]
- Spagnoli, D.; Allen, J.P.; Parker, S.C. The Structure and Dynamics of Hydrated and Hydroxylated Magnesium Oxide Nanoparticles. Langmuir 2011, 27, 1821–1829. [Google Scholar] [CrossRef] [PubMed]
- Sohrabi, L.; Taleshi, F. Effect of carbon nanotubes support on band gap energy of MgO nanoparticles. J. Mater. Sci. Mater. Electron. 2014, 25, 4110–4114. [Google Scholar] [CrossRef]
- Kumar, A.; Kumar, J. On the synthesis and optical absorption studies of nano-size magnesium oxide powder. J. Phys. Chem. Solids 2008, 69, 2764–2772. [Google Scholar] [CrossRef]
- Mao, Z.; Vang, H.; Garcia, A.; Tohti, A.; Stokes, B.J.; Nguyen, S.C. Carrier Diffusion—The Main Contribution to Size-Dependent Photocatalytic Activity of Colloidal Gold Nanoparticles. ACS Catal. 2019, 9, 4211–4217. [Google Scholar] [CrossRef]
- Akhavan, O.; Ghaderi, E. Graphene Nanomesh Promises Extremely Efficient In Vivo Photothermal Therapy. Small 2013, 9, 3593–3601. [Google Scholar] [CrossRef] [PubMed]
- Shaheen, T.I.; Fouda, A.; Salem, S.S. Integration of Cotton Fabrics with Biosynthesized CuO Nanoparticles for Bactericidal Activity in the Terms of Their Cytotoxicity Assessment. Ind. Eng. Chem. Res. 2021, 60, 1553–1563. [Google Scholar] [CrossRef]
- Akhavan, O.; Ghaderi, E.; Shirazian, S.A. Near infrared laser stimulation of human neural stem cells into neurons on graphene nanomesh semiconductors. Colloids Surf. B Biointerfaces 2015, 126, 313–321. [Google Scholar] [CrossRef] [PubMed]
- Zare, I.; Yaraki, M.T.; Speranza, G.; Najafabadi, A.H.; Shourangiz-Haghighi, A.; Nik, A.B.; Manshian, B.B.; Saraiva, C.; Soenen, S.J.; Kogan, M.J.; et al. Gold nanostructures: Synthesis, properties, and neurological applications. Chem. Soc. Rev. 2022, 51, 2601–2680. [Google Scholar] [CrossRef]
- Zare, I.; Chevrier, D.M.; Cifuentes-Rius, A.; Moradi, N.; Xianyu, Y.; Ghosh, S.; Trapiella-Alfonso, L.; Tian, Y.; Shourangiz-Haghighi, A.; Mukherjee, S.; et al. Protein-protected metal nanoclusters as diagnostic and therapeutic platforms for biomedical applications. Mater. Today 2021, in press. [Google Scholar] [CrossRef]
- Kolahalam, L.A.; Viswanath, I.K.; Diwakar, B.S.; Govindh, B.; Reddy, V.; Murthy, Y. Review on nanomaterials: Synthesis and applications. Mater. Today Proc. 2019, 18, 2182–2190. [Google Scholar] [CrossRef]
- Farani, M.R.; Jahromi, N.A.; Ali, V.; Ebrahimpour, A.; Salehian, E.; Ardestani, M.S.; Seyedhamzeh, M.; Ahmadi, S.; Sharifi, E.; Ashrafizadeh, M.; et al. Detection of Dopamine Receptors Using Nanoscale Dendrimer for Potential Application in Targeted Delivery and Whole-Body Imaging: Synthesis and In Vivo Organ Distribution. ACS Appl. Bio Mater. 2022, 5, 1744–1755. [Google Scholar] [CrossRef]
- Farani, M.R.; Jiang, X.P. Advances of Nanotechnology in Regenerative Medicine; Rose Publication PTY LTD: Melbourne, Australia, 2022. [Google Scholar]
- Alrashed, A.A.; Akbari, O.A.; Heydari, A.; Toghraie, D.; Zarringhalam, M.; Shabani, G.A.S.; Seifi, A.R.; Goodarzi, M. The numerical modeling of water/FMWCNT nanofluid flow and heat transfer in a backward-facing contracting channel. Phys. B Condens. Matter 2018, 537, 176–183. [Google Scholar] [CrossRef]
- Farani, M.R.; Khiarak, B.N.; Tao, R.; Wang, Z.; Ahmadi, S.; Hassanpour, M.; Rabiee, M.; Saeb, M.R.; Lima, E.C.; Rabiee, N. 2D MXene nanocomposites: Electrochemical and biomedical applications. Environ. Sci. Nano 2022, 9, 4038–4068. [Google Scholar] [CrossRef]
- Ray, P.C.; Yu, H.; Fu, P.P. Toxicity and Environmental Risks of Nanomaterials: Challenges and Future Needs. J. Environ. Sci. Health Part C 2009, 27, 1–35. [Google Scholar] [CrossRef]
- Prasanth, R.; Kumar, S.D.; Jayalakshmi, A.; Singaravelu, G.; Govindaraju, K.; Kumar, V.G. Green synthesis of magnesium oxide nanoparticles and their antibacterial activity. Indian J. Geo Mar. Sci. 2019, 48, 1210–1215. [Google Scholar]
- Meng, X.; Zare, I.; Yan, X.; Fan, K. Protein-protected metal nanoclusters: An emerging ultra-small nanozyme. Wiley Interdiscip. Rev. Nanomed. Nanobiotechnol. 2020, 12, e1602. [Google Scholar] [CrossRef]
- Akhavan, O.; Bijanzad, K.; Mirsepah, A. Synthesis of graphene from natural and industrial carbonaceous wastes. RSC Adv. 2014, 4, 20441–20448. [Google Scholar] [CrossRef]
- Khan, F.; Shahid, A.; Zhu, H.; Wang, N.; Javed, M.R.; Ahmad, N.; Xu, J.; Alam, M.; Mehmood, M.A. Prospects of algae-based green synthesis of nanoparticles for environmental applications. Chemosphere 2022, 293, 133571. [Google Scholar] [CrossRef]
- Chellamuthu, P.; Tran, F.; Silva, K.P.T.; Chavez, M.S.; El-Naggar, M.Y.; Boedicker, J.Q. Engineering bacteria for biogenic synthesis of chalcogenide nanomaterials. Microb. Biotechnol. 2018, 12, 161–172. [Google Scholar] [CrossRef]
- Adil, S.F.; Assal, M.E.; Khan, M.; Al-Warthan, A.; Siddiqui, M.R.H.; Liz-Marzán, L.M. Biogenic synthesis of metallic nanoparticles and prospects toward green chemistry. Dalton Trans. 2015, 44, 9709–9717. [Google Scholar] [CrossRef]
- Nejati, M.; Rostami, M.; Mirzaei, H.; Rahimi-Nasrabadi, M.; Vosoughifar, M.; Nasab, A.S.; Ganjali, M.R. Green methods for the preparation of MgO nanomaterials and their drug delivery, anti-cancer and anti-bacterial potentials: A review. Inorg. Chem. Commun. 2021, 136, 109107. [Google Scholar] [CrossRef]
- Fouda, A.; Hassan, S.E.-D.; Saied, E.; Azab, M.S. An eco-friendly approach to textile and tannery wastewater treatment using maghemite nanoparticles (γ-Fe2O3-NPs) fabricated by Penicillium expansum strain (K-w). J. Environ. Chem. Eng. 2020, 9, 104693. [Google Scholar] [CrossRef]
- Nguyen, N.T.T.; Nguyen, L.M.; Nguyen, T.T.T.; Tran, U.P.; Nguyen, D.T.C.; Van Tran, T. A critical review on the bio-mediated green synthesis and multiple applications of magnesium oxide nanoparticles. Chemosphere 2023, 312, 137301. [Google Scholar] [CrossRef] [PubMed]
- Feng, T.; Zhang, M.; Sun, Q.; Mujumdar, A.S.; Yu, D. Extraction of functional extracts from berries and their high quality processing: A comprehensive review. Crit. Rev. Food Sci. Nutr. 2022, 1–18. [Google Scholar] [CrossRef]
- Yaraki, M.T.; Nasab, S.Z.; Zare, I.; Dahri, M.; Sadeghi, M.M.; Koohi, M.; Tan, Y.N. Biomimetic Metallic Nanostructures for Biomedical Applications, Catalysis, and Beyond. Ind. Eng. Chem. Res. 2022, 61, 7547–7593. [Google Scholar] [CrossRef]
- Kulkarni, N.; Muddapur, U. Biosynthesis of Metal Nanoparticles: A Review. J. Nanotechnol. 2014, 2014, 510246. [Google Scholar] [CrossRef]
- Khan, F.; Shariq, M.; Asif, M.; Siddiqui, M.A.; Malan, P.; Ahmad, F. Green Nanotechnology: Plant-Mediated Nanoparticle Synthesis and Application. Nanomaterials 2022, 12, 673. [Google Scholar] [CrossRef]
- Rabiee, N.; Fatahi, Y.; Asadnia, M.; Daneshgar, H.; Kiani, M.; Ghadiri, A.M.; Atarod, M.; Mashhadzadeh, A.H.; Akhavan, O.; Bagherzadeh, M.; et al. Green porous benzamide-like nanomembranes for hazardous cations detection, separation, and concentration adjustment. J. Hazard. Mater. 2021, 423, 127130. [Google Scholar] [CrossRef] [PubMed]
- Akhavan, O.; Kalaee, M.; Alavi, Z.; Ghiasi, S.; Esfandiar, A. Increasing the antioxidant activity of green tea polyphenols in the presence of iron for the reduction of graphene oxide. Carbon 2012, 50, 3015–3025. [Google Scholar] [CrossRef]
- Abubakar, A.R.; Haque, M. Preparation of medicinal plants: Basic extraction and fractionation procedures for experimental purposes. J. Pharm. Bioallied Sci. 2020, 12, 1–10. [Google Scholar] [CrossRef]
- Jouyandeh, M.; Tavakoli, O.; Sarkhanpour, R.; Sajadi, S.M.; Zarrintaj, P.; Rabiee, N.; Akhavan, O.; Lima, E.C.; Saeb, M.R. Green products from herbal medicine wastes by subcritical water treatment. J. Hazard. Mater. 2021, 424, 127294. [Google Scholar] [CrossRef] [PubMed]
- Pandey, A.; Tripathi, S. Concept of standardization, extraction and pre phytochemical screening strategies for herbal drug. J. Pharmacogn. Phytochem. 2014, 2, 115–119. [Google Scholar]
- Altemimi, A.; Lakhssassi, N.; Baharlouei, A.; Watson, D.G.; Lightfoot, D.A. Phytochemicals: Extraction, Isolation, and Identification of Bioactive Compounds from Plant Extracts. Plants 2017, 6, 42. [Google Scholar] [CrossRef]
- Das, K.; Tiwari, R.; Shrivastava, D. Techniques for evaluation of medicinal plant products as antimicrobial agent: Current methods and future trends. J. Med. Plants Res. 2010, 4, 104–111. [Google Scholar]
- Eloff, J. Which extractant should be used for the screening and isolation of antimicrobial components from plants? J. Ethnopharmacol. 1998, 60, 1–8. [Google Scholar] [CrossRef] [PubMed]
- Muthu, K.; Priya, S. Green synthesis, characterization and catalytic activity of silver nanoparticles using Cassia auriculata flower extract separated fraction. Spectrochim. Acta Part A Mol. Biomol. Spectrosc. 2017, 179, 66–72. [Google Scholar] [CrossRef] [PubMed]
- Ramesh, A.; Devi, D.R.; Battu, G.; Basavaiah, K. A Facile plant mediated synthesis of silver nanoparticles using an aqueous leaf extract of Ficus hispida Linn. f. for catalytic, antioxidant and antibacterial applications. S. Afr. J. Chem. Eng. 2018, 26, 25–34. [Google Scholar] [CrossRef]
- Lee, K.X.; Shameli, K.; Mohamad, S.E.; Yew, Y.P.; Isa, E.D.M.; Yap, H.-Y.; Lim, W.L.; Teow, S.-Y. Bio-Mediated Synthesis and Characterisation of Silver Nanocarrier, and Its Potent Anticancer Action. Nanomaterials 2019, 9, 1423. [Google Scholar] [CrossRef]
- Fayaz, A.M.; Balaji, K.; Kalaichelvan, P.; Venkatesan, R. Fungal based synthesis of silver nanoparticles—An effect of temperature on the size of particles. Colloids Surf. B Biointerfaces 2009, 74, 123–126. [Google Scholar] [CrossRef]
- Jeevanandam, J.; Chan, Y.S.; Danquah, M.K. Cytotoxicity and insulin resistance reversal ability of biofunctional phytosynthesized MgO nanoparticles. 3 Biotech 2020, 10, 1–15. [Google Scholar] [CrossRef]
- Das, B.; Moumita, S.; Ghosh, S.; Khan, I.; Indira, D.; Jayabalan, R.; Tripathy, S.K.; Mishra, A.; Balasubramanian, P. Biosynthesis of magnesium oxide (MgO) nanoflakes by using leaf extract of Bauhinia purpurea and evaluation of its antibacterial property against Staphylococcus aureus. Mater. Sci. Eng. C 2018, 91, 436–444. [Google Scholar] [CrossRef]
- Abdullah, O.H.; Mohammed, A.M. Biosynthesis and characterization of MgO nanowires using Prosopis farcta and evaluation of their applications. Inorg. Chem. Commun. 2020, 125, 108435. [Google Scholar] [CrossRef]
- Sharmila, G.; Muthukumaran, C.; Sangeetha, E.; Saraswathi, H.; Soundarya, S.; Kumar, N.M. Green fabrication, characterization of Pisonia alba leaf extract derived MgO nanoparticles and its biological applications. Nano-Struct. Nano-Objects 2019, 20. [Google Scholar] [CrossRef]
- Ogunyemi, S.O.; Zhang, F.; Abdallah, Y.; Zhang, M.; Wang, Y.; Sun, G.; Qiu, W.; Li, B. Biosynthesis and characterization of magnesium oxide and manganese dioxide nanoparticles using Matricaria chamomilla L. extract and its inhibitory effect on Acidovorax oryzae strain RS-2. Artif. Cells Nanomed. Biotechnol. 2019, 47, 2230–2239. [Google Scholar] [CrossRef]
- Kaul, R.K.; Kumar, P.; Burman, U.; Joshi, P.; Agrawal, A.; Raliya, R.; Tarafdar, J.C. Magnesium and iron nanoparticles production using microorganisms and various salts. Mater. Sci. 2012, 30, 254–258. [Google Scholar] [CrossRef]
- Nijalingappa, T.; Veeraiah, M.; Basavaraj, R.; Darshan, G.; Sharma, S.; Nagabhushana, H. Antimicrobial properties of green synthesis of MgO micro architectures via Limonia acidissima fruit extract. Biocatal. Agric. Biotechnol. 2019, 18, 100991. [Google Scholar] [CrossRef]
- Vijayakumar, S.; Punitha, V.N.; Parameswari, N. Phytonanosynthesis of MgO Nanoparticles: Green Synthesis, Characterization and Antimicrobial Evaluation. Arab. J. Sci. Eng. 2021, 47, 6729–6734. [Google Scholar] [CrossRef]
- Sharma, S.K.; Khan, A.U.; Khan, M.; Gupta, M.; Gehlot, A.; Park, S.; Alam, M. Biosynthesis of MgO nanoparticles using Annona squamosa seeds and its catalytic activity and antibacterial screening. Micro Nano Lett. 2020, 15, 30–34. [Google Scholar] [CrossRef]
- Kumar, M.A.; Mahendra, B.; Nagaswarupa, H.; Surendra, B.; Ravikumar, C.; Shetty, K. Photocatalytic Studies of MgO Nano Powder; Synthesized by Green Mediated Route. Mater. Today Proc. 2018, 5, 22221–22228. [Google Scholar] [CrossRef]
- Dobrucka, R. Synthesis of MgO Nanoparticles Using Artemisia abrotanum Herba Extract and Their Antioxidant and Photocatalytic Properties. Iran. J. Sci. Technol. Trans. A Sci. 2016, 42, 547–555. [Google Scholar] [CrossRef]
- Khan, A.; Shabir, D.; Ahmad, P.; Khandaker, M.U.; Faruque, M.; Din, I.U. Biosynthesis and antibacterial activity of MgO-NPs produced from Camellia-sinensis leaves extract. Mater. Res. Express 2020, 8, 015402. [Google Scholar] [CrossRef]
- Jeevanandam, J.; Chan, Y.S.; Wong, Y.J.; Hii, Y.S. Biogenic synthesis of magnesium oxide nanoparticles using Aloe barbadensis leaf latex extract. IOP Conf. Ser. Mater. Sci. Eng. 2020, 943, 012030. [Google Scholar] [CrossRef]
- Dabhane, H.; Ghotekar, S.; Zate, M.; Kute, S.; Jadhav, G.; Medhane, V. Green synthesis of MgO nanoparticles using aqueous leaf extract of Ajwain (Trachyspermum ammi) and evaluation of their catalytic and biological activities. Inorg. Chem. Commun. 2022, 138, 109270. [Google Scholar] [CrossRef]
- Khan, M.A.; Ali, F.; Faisal, S.; Rizwan, M.; Hussain, Z.; Zaman, N.; Afsheen, Z.; Uddin, M.N.; Bibi, N. Exploring the therapeutic potential of Hibiscus rosa sinensis synthesized cobalt oxide (Co3O4-NPs) and magnesium oxide nanoparticles (MgO-NPs). Saudi J. Biol. Sci. 2021, 28, 5157–5167. [Google Scholar]
- Ammulu, M.A.; Viswanath, K.V.; Giduturi, A.K.; Vemuri, P.K.; Mangamuri, U.; Poda, S. Phytoassisted synthesis of magnesium oxide nanoparticles from Pterocarpus marsupium rox.b heartwood extract and its biomedical applications. J. Genet. Eng. Biotechnol. 2021, 19, 1–18. [Google Scholar] [CrossRef]
- Abdallah, Y.; Ogunyemi, S.O.; Abdelazez, A.; Zhang, M.; Hong, X.; Ibrahim, E.; Hossain, A.; Fouad, H.; Li, B.; Chen, J. The Green Synthesis of MgO Nano-Flowers Using Rosmarinus officinalis L. (Rosemary) and the Antibacterial Activities against Xanthomonas oryzae pv. oryzae. BioMed Res. Int. 2019, 2019, 5620989. [Google Scholar] [CrossRef]
- Poonguzhali, R.V.; Srimathi, M.; Kumar, E.R.; Arunadevi, N.; Elansary, H.O.; Abdelbacki, A.A.; Abdelmohsen, S.A. Citrus limon assisted green synthesis of MgO nanoparticles: Evaluation of phase, functional groups, surface morphology, thermal stability and colloidal stability. Ceram. Int. 2022, 48, 27774–27778. [Google Scholar] [CrossRef]
- Amina, M.; Al Musayeib, N.M.; Alarfaj, N.A.; El-Tohamy, M.F.; Oraby, H.F.; Al Hamoud, G.A.; Bukhari, S.I.; Moubayed, N.M.S. Biogenic green synthesis of MgO nanoparticles using Saussurea costus biomasses for a comprehensive detection of their antimicrobial, cytotoxicity against MCF-7 breast cancer cells and photocatalysis potentials. PLoS ONE 2020, 15, e0237567. [Google Scholar] [CrossRef]
- Saravanan, A.; Kumar, P.S.; Karishma, S.; Vo, D.-V.N.; Jeevanantham, S.; Yaashikaa, P.; George, C.S. A review on biosynthesis of metal nanoparticles and its environmental applications. Chemosphere 2020, 264, 128580. [Google Scholar] [CrossRef]
- Gahlawat, G.; Choudhury, A.R. A review on the biosynthesis of metal and metal salt nanoparticles by microbes. RSC Adv. 2019, 9, 12944–12967. [Google Scholar] [CrossRef]
- Jacob, J.M.; Lens, P.N.L.; Balakrishnan, R.M. Microbial synthesis of chalcogenide semiconductor nanoparticles: A review. Microb. Biotechnol. 2015, 9, 11–21. [Google Scholar] [CrossRef]
- Banik, A.; Vadivel, M.; Mondal, M.; Sakthivel, N. Molecular Mechanisms that Mediate Microbial Synthesis of Metal Nanoparticles. In Microbial Metabolism of Metals and Metalloids; Springer: Cham, Switzerland, 2022; pp. 135–166. [Google Scholar] [CrossRef]
- Mohanasrinivasan, V.; Devi, C.S.; Mehra, A.; Prakash, S.; Agarwal, A.; Selvarajan, E.; Naine, S.J. Biosynthesis of MgO Nanoparticles Using Lactobacillus Sp. and its Activity Against Human Leukemia Cell Lines HL-60. Bionanoscience 2017, 8, 249–253. [Google Scholar] [CrossRef]
- Barabadi, H.; Ovais, M.; Shinwari, Z.K.; Saravanan, M. Anti-cancer green bionanomaterials: Present status and future prospects. Green Chem. Lett. Rev. 2017, 10, 285–314. [Google Scholar] [CrossRef]
- Fouda, A.; Awad, M.A.; Eid, A.M.; Saied, E.; Barghoth, M.G.; Hamza, M.F.; Abdelbary, S.; Hassan, S.E.-D. An Eco-Friendly Approach to the Control of Pathogenic Microbes and Anopheles stephensi Malarial Vector Using Magnesium Oxide Nanoparticles (Mg-NPs) Fabricated by Penicillium chrysogenum. Int. J. Mol. Sci. 2021, 22, 5096. [Google Scholar] [CrossRef] [PubMed]
- Pugazhendhi, A.; Prabhu, R.; Muruganantham, K.; Shanmuganathan, R.; Natarajan, S. Anticancer, antimicrobial and photocatalytic activities of green synthesized magnesium oxide nanoparticles (MgONPs) using aqueous extract of Sargassum wightii. J. Photochem. Photobiol. B Biol. 2018, 190, 86–97. [Google Scholar] [CrossRef]
- Balraj, B.; Senthilkumar, N.; Potheher, I.V.; Arulmozhi, M. Characterization, antibacterial, anti-arthritic and in-vitro cytotoxic potentials of biosynthesized Magnesium Oxide nanomaterial. Mater. Sci. Eng. B 2018, 231, 121–127. [Google Scholar] [CrossRef]
- Ahmed, T.; Noman, M.; Shahid, M.; Li, B. Antibacterial potential of green magnesium oxide nanoparticles against rice pathogen Acidovorax oryzae. Mater. Lett. 2020, 282, 128839. [Google Scholar] [CrossRef]
- Saravanakumar, K.; Wang, M.-H. Biogenic silver embedded magnesium oxide nanoparticles induce the cytotoxicity in human prostate cancer cells. Adv. Powder Technol. 2019, 30, 786–794. [Google Scholar] [CrossRef]
- Fouda, A.; Hassan, S.E.-D.; Abdel-Rahman, M.A.; Farag, M.M.; Shehal-Deen, A.; Mohamed, A.A.; Alsharif, S.M.; Saied, E.; Moghanim, S.A.; Azab, M.S. Catalytic degradation of wastewater from the textile and tannery industries by green synthesized hematite (α-Fe2O3) and magnesium oxide (MgO) nanoparticles. Curr. Res. Biotechnol. 2021, 3, 29–41. [Google Scholar] [CrossRef]
- Hassan, S.E.-D.; Fouda, A.; Saied, E.; Farag, M.M.; Eid, A.M.; Barghoth, M.G.; Awad, M.A.; Hamza, M.F.; Awad, M.F. Rhizopus Oryzae-mediated green synthesis of magnesium oxide nanoparticles (MgO-NPs): A promising tool for antimicrobial, mosquitocidal action, and tanning effluent treatment. J. Fungi 2021, 7, 372. [Google Scholar] [CrossRef]
- Abdel-Aziz, M.M.; Emam, T.; Elsherbiny, E.A. Bioactivity of magnesium oxide nanoparticles synthesized from cell filtrate of endobacterium Burkholderia rinojensis against Fusarium oxysporum. Mater. Sci. Eng. C 2019, 109, 110617. [Google Scholar] [CrossRef] [PubMed]
- Das, S.K.; Dickinson, C.; Lafir, F.; Brougham, D.F.; Marsili, E. Synthesis, characterization and catalytic activity of gold nanoparticles biosynthesized with Rhizopus oryzae protein extract. Green Chem. 2012, 14, 1322–1334. [Google Scholar] [CrossRef]
- Kitching, M.; Ramani, M.; Marsili, E. Fungal biosynthesis of gold nanoparticles: Mechanism and scale up. Microb. Biotechnol. 2014, 8, 904–917. [Google Scholar] [CrossRef] [PubMed]
- Jhansi, K.; Jayarambabu, N.; Reddy, K.P.; Reddy, N.M.; Suvarna, R.P.; Rao, K.V.; Kumar, V.R.; Rajendar, V. Biosynthesis of MgO nanoparticles using mushroom extract: Effect on peanut (Arachis hypogaea L.) seed germination. 3 Biotech 2017, 7, 263. [Google Scholar] [CrossRef]
- Jeevanandam, J.; Chan, Y.S.; Danquah, M.K. Biosynthesis and characterization of MgO nanoparticles from plant extracts via induced molecular nucleation. New J. Chem. 2017, 41, 2800–2814. [Google Scholar] [CrossRef]
- Bérdy, J. Bioactive Microbial Metabolites. J. Antibiot. 2005, 58, 1–26. [Google Scholar] [CrossRef]
- Ahluwalia, V.; Kumar, J.; Sisodia, R.; Shakil, N.A.; Walia, S. Green synthesis of silver nanoparticles by Trichoderma harzianum and their bio-efficacy evaluation against Staphylococcus aureus and Klebsiella pneumonia. Ind. Crop. Prod. 2014, 55, 202–206. [Google Scholar] [CrossRef]
- Castro-Longoria, E.; Vilchis-Nestor, A.R.; Avalos-Borja, M. Biosynthesis of silver, gold and bimetallic nanoparticles using the filamentous fungus Neurospora crassa. Colloids Surf. B Biointerfaces 2011, 83, 42–48. [Google Scholar] [CrossRef]
- Molnár, Z.; Bódai, V.; Szakacs, G.; Erdélyi, B.; Fogarassy, Z.; Sáfrán, G.; Varga, T.; Kónya, Z.; Tóth-Szeles, E.; Szűcs, R.; et al. Green synthesis of gold nanoparticles by thermophilic filamentous fungi. Sci. Rep. 2018, 8, 1–12. [Google Scholar] [CrossRef]
- Azmath, P.; Baker, S.; Rakshith, D.; Satish, S. Mycosynthesis of silver nanoparticles bearing antibacterial activity. Saudi Pharm. J. 2016, 24, 140–146. [Google Scholar] [CrossRef] [PubMed]
- Gudikandula, K.; Vadapally, P.; Charya, M.S. Biogenic synthesis of silver nanoparticles from white rot fungi: Their characterization and antibacterial studies. Opennano 2017, 2, 64–78. [Google Scholar] [CrossRef]
- Qamar, S.U.R.; Ahmad, J.N. Nanoparticles: Mechanism of biosynthesis using plant extracts, bacteria, fungi, and their applications. J. Mol. Liq. 2021, 334, 116040. [Google Scholar] [CrossRef]
- Saied, E.; Eid, A.M.; Hassan, S.E.-D.; Salem, S.S.; Radwan, A.A.; Halawa, M.; Saleh, F.M.; Saad, H.A.; Saied, E.M.; Fouda, A. The catalytic activity of biosynthesized magnesium oxide nanoparticles (Mgo-nps) for inhibiting the growth of pathogenic microbes, tanning effluent treatment, and chromium ion removal. Catalysts 2021, 11, 821. [Google Scholar] [CrossRef]
- Balakumaran, M.; Ramachandran, R.; Kalaichelvan, P. Exploitation of endophytic fungus, Guignardia mangiferae for extracellular synthesis of silver nanoparticles and their in vitro biological activities. Microbiol. Res. 2015, 178, 9–17. [Google Scholar] [CrossRef]
- Birla, S.S.; Gaikwad, S.C.; Gade, A.K.; Rai, M.K. Rapid synthesis of silver nanoparticles from Fusarium oxysporum by optimizing physicocultural conditions. Sci. World J. 2013, 2013, 796018. [Google Scholar] [CrossRef]
- Silva, L.P.C.; Oliveira, J.P.; Keijok, W.J.; da Silva, A.R.; Aguiar, A.R.; Guimarães, M.C.C.; Ferraz, C.M.; Araújo, J.V.; Tobias, F.L.; Braga, F.R. Extracellular biosynthesis of silver nanoparticles using the cell-free filtrate of nematophagous fungus Duddingtonia flagrans. Int. J. Nanomed. 2017, 12, 6373–6381. [Google Scholar] [CrossRef]
- Saxena, J.; Sharma, P.K.; Sharma, M.M.; Singh, A. Process optimization for green synthesis of silver nanoparticles by Sclerotinia sclerotiorum MTCC 8785 and evaluation of its antibacterial properties. Springerplus 2016, 5, 1–10. [Google Scholar] [CrossRef] [PubMed]
- Kanniah, P.; Chelliah, P.; Thangapandi, J.R.; Thangapandi, E.J.J.S.B.; Kasi, M.; Sivasubramaniam, S. Benign fabrication of metallic/metal oxide nanoparticles from algae. In Agri-Waste and Microbes for Production of Sustainable Nanomaterials; Elsevier: Amsterdam, The Netherlands, 2022; pp. 465–493. [Google Scholar]
- Asmathunisha, N.; Kathiresan, K. A review on biosynthesis of nanoparticles by marine organisms. Colloids Surf. B Biointerfaces 2013, 103, 283–287. [Google Scholar] [CrossRef]
- Eroglu, E.; Chen, X.; Bradshaw, M.; Agarwal, V.; Zou, J.; Stewart, S.G.; Duan, X.; Lamb, R.N.; Smith, S.M.; Raston, C.L.; et al. Biogenic production of palladium nanocrystals using microalgae and their immobilization on chitosan nanofibers for catalytic applications. RSC Adv. 2012, 3, 1009–1012. [Google Scholar] [CrossRef]
- Dahoumane, S.A.; Mechouet, M.; Wijesekera, K.; Filipe, C.D.M.; Sicard, C.; Bazylinski, D.A.; Jeffryes, C. Algae-mediated biosynthesis of inorganic nanomaterials as a promising route in nanobiotechnology—A review. Green Chem. 2016, 19, 552–587. [Google Scholar] [CrossRef]
- Sharma, A.; Sharma, S.; Sharma, K.; Chetri, S.P.K.; Vashishtha, A.; Singh, P.; Kumar, R.; Rathi, B.; Agrawal, V. Algae as crucial organisms in advancing nanotechnology: A systematic review. J. Appl. Phycol. 2015, 28, 1759–1774. [Google Scholar] [CrossRef]
- Vijayan, S.R.; Santhiyagu, P.; Ramasamy, R.; Arivalagan, P.; Kumar, G.; Ethiraj, K.; Ramaswamy, B.R. Seaweeds: A resource for marine bionanotechnology. Enzym. Microb. Technol. 2016, 95, 45–57. [Google Scholar] [CrossRef] [PubMed]
- Siddiqui, M.N.; Redhwi, H.H.; Achilias, D.S.; Kosmidou, E.; Vakalopoulou, E.; Ioannidou, M.D. Green Synthesis of Silver Nanoparticles and Study of Their Antimicrobial Properties. J. Polym. Environ. 2017, 26, 423–433. [Google Scholar] [CrossRef]
- Khalil, M.M.H.; Ismail, E.H.; El-Baghdady, K.Z.; Mohamed, D. Green synthesis of silver nanoparticles using olive leaf extract and its antibacterial activity. Arab. J. Chem. 2014, 7, 1131–1139. [Google Scholar] [CrossRef]
- Fouda, A.; Eid, A.M.; Abdel-Rahman, M.A.; El-Belely, E.F.; Awad, M.A.; Hassan, S.E.-D.; Al-Faifi, Z.E.; Hamza, M.F. Enhanced Antimicrobial, Cytotoxicity, Larvicidal, and Repellence Activities of Brown Algae, Cystoseira crinita-Mediated Green Synthesis of Magnesium Oxide Nanoparticles. Front. Bioeng. Biotechnol. 2022, 10, 849921. [Google Scholar] [CrossRef]
- Akhavan, O.; Ghaderi, E. Toxicity of graphene and graphene oxide nanowalls against bacteria. ACS Nano 2010, 4, 5731–5736. [Google Scholar] [CrossRef]
- Dutta, T.; Sarkar, R.; Pakhira, B.; Ghosh, S.; Sarkar, R.; Barui, A.; Sarkar, S. ROS generation by reduced graphene oxide (rGO) induced by visible light showing antibacterial activity: Comparison with graphene oxide (GO). RSC Adv. 2015, 5, 80192–80195. [Google Scholar] [CrossRef]
- Prasanna, V.L.; Vijayaraghavan, R. Insight into the Mechanism of Antibacterial Activity of ZnO: Surface Defects Mediated Reactive Oxygen Species Even in the Dark. Langmuir 2015, 31, 9155–9162. [Google Scholar] [CrossRef]
- Akhavan, O.; Ghaderi, E. Cu and CuO nanoparticles immobilized by silica thin films as antibacterial materials and photocatalysts. Surf. Coatings Technol. 2010, 205, 219–223. [Google Scholar] [CrossRef]
- Wang, L.; Hu, C.; Shao, L. The antimicrobial activity of nanoparticles: Present situation and prospects for the future. Int. J. Nanomed. 2017, 12, 1227–1249. [Google Scholar] [CrossRef] [PubMed]
- Jannesari, M.; Akhavan, O.; Hosseini, H.R.M.; Bakhshi, B. Graphene/CuO2 Nanoshuttles with Controllable Release of Oxygen Nanobubbles Promoting Interruption of Bacterial Respiration. ACS Appl. Mater. Interfaces 2020, 12, 35813–35825. [Google Scholar] [CrossRef]
- Ananda, A.; Ramakrishnappa, T.; Archana, S.; Yadav, L.R.; Shilpa, B.; Nagaraju, G.; Jayanna, B. Green synthesis of MgO nanoparticles using Phyllanthus emblica for Evans blue degradation and antibacterial activity. Mater. Today Proc. 2021, 49, 801–810. [Google Scholar] [CrossRef]
- Koper, O.B.; Klabunde, J.S.; Marchin, G.L.; Klabunde, K.J.; Stoimenov, P.; Bohra, L. Nanoscale Powders and Formulations with Biocidal Activity Toward Spores and Vegetative Cells of Bacillus Species, Viruses, and Toxins. Curr. Microbiol. 2002, 44, 49–55. [Google Scholar] [CrossRef]
- Koper, O.B.; Lagadic, I.; Volodin, A.; Klabunde, K.J. Alkaline-Earth Oxide Nanoparticles Obtained by Aerogel Methods. Characterization and Rational for Unexpectedly High Surface Chemical Reactivities. Chem. Mater. 1997, 9, 2468–2480. [Google Scholar] [CrossRef]
- Stoimenov, P.K.; Klinger, R.L.; Marchin, G.L.; Klabunde, K.J. Metal Oxide Nanoparticles as Bactericidal Agents. Langmuir 2002, 18, 6679–6686. [Google Scholar] [CrossRef]
- Tang, Z.-X.; Lv, B.-F. MgO nanoparticles as antibacterial agent: Preparation and activity. Braz. J. Chem. Eng. 2014, 31, 591–601. [Google Scholar] [CrossRef]
- Huang, L.; Li, D.-Q.; Lin, Y.-J.; Wei, M.; Evans, D.G.; Duan, X. Controllable preparation of Nano-MgO and investigation of its bactericidal properties. J. Inorg. Biochem. 2005, 99, 986–993. [Google Scholar] [CrossRef] [PubMed]
- Yamamoto, O.; Sawai, J.; Sasamoto, T. Change in antibacterial characteristics with doping amount of ZnO in MgO–ZnO solid solution. Int. J. Inorg. Mater. 2000, 2, 451–454. [Google Scholar] [CrossRef]
- Sawai, J.; Shoji, S.; Igarashi, H.; Hashimoto, A.; Kokugan, T.; Shimizu, M.; Kojima, H. Hydrogen peroxide as an antibacterial factor in zinc oxide powder slurry. J. Ferment. Bioeng. 1998, 86, 521–522. [Google Scholar] [CrossRef]
- Nguyen, N.-Y.T.; Grelling, N.; Wetteland, C.L.; Rosario, R.; Liu, H.N. Antimicrobial Activities and Mechanisms of Magnesium Oxide Nanoparticles (nMgO) against Pathogenic Bacteria, Yeasts, and Biofilms. Sci. Rep. 2018, 8, 16260. [Google Scholar] [CrossRef] [PubMed]
- Treccani, L. Interactions Between Surface Material and Bacteria: From Biofilm Formation to Suppression. In Surface-Functionalized Ceramics: For Biotechnological and Environmental Applications; Wiley: Hoboken, NJ, USA, 2022; pp. 283–335. [Google Scholar] [CrossRef]
- Vestby, L.K.; Grønseth, T.; Simm, R.; Nesse, L.L. Bacterial Biofilm and its Role in the Pathogenesis of Disease. Antibiotics 2020, 9, 59. [Google Scholar] [CrossRef] [PubMed]
- Pintucci, J.P.; Corno, S.; Garotta, M. Biofilms and infections of the upper respiratory tract. Eur. Rev. Med Pharmacol. Sci. 2010, 14, 683–690. [Google Scholar] [PubMed]
- Donlan, R.M. Biofilms and Device-Associated Infections. Emerg. Infect. Dis. 2001, 7, 277–281. [Google Scholar] [CrossRef] [PubMed]
- Lewis, K. Riddle of Biofilm Resistance. Antimicrob. Agents Chemother. 2001, 45, 999–1007. [Google Scholar] [CrossRef] [PubMed]
- Ramasamy, M.; Lee, J.-H.; Lee, J. Potent antimicrobial and antibiofilm activities of bacteriogenically synthesized gold–silver nanoparticles against pathogenic bacteria and their physiochemical characterizations. J. Biomater. Appl. 2016, 31, 366–378. [Google Scholar] [CrossRef] [PubMed]
- Younis, I.Y.; El-Hawary, S.S.; Eldahshan, O.A.; Abdel-Aziz, M.M.; Ali, Z.Y. Green synthesis of magnesium nanoparticles mediated from Rosa floribunda charisma extract and its antioxidant, antiaging and antibiofilm activities. Sci. Rep. 2021, 11, 16868. [Google Scholar] [CrossRef]
- Shankar, S.; Murthy, A.N.; Rachitha, P.; Raghavendra, V.B.; Sunayana, N.; Chinnathambi, A.; Alharbi, S.A.; Basavegowda, N.; Brindhadevi, K.; Pugazhendhi, A. Biosynthesis of silk sericin conjugated magnesium oxide nanoparticles for its antioxidant, antiaging, and anti-biofilm activities. Environ. Res. 2023, 223, 115421. [Google Scholar] [CrossRef]
- Campoccia, D.; Montanaro, L.; Arciola, C.R. The significance of infection related to orthopedic devices and issues of antibiotic resistance. Biomaterials 2006, 27, 2331–2339. [Google Scholar] [CrossRef]
- Jin, T.; He, Y. Antibacterial activities of magnesium oxide (MgO) nanoparticles against foodborne pathogens. J. Nanoparticle Res. 2011, 13, 6877–6885. [Google Scholar] [CrossRef]
- Bhabra, G.; Sood, A.D.; Fisher, B.; Cartwright, L.; Saunders, M.; Evans, W.H.; Surprenant, A.; Lopez-Castejon, G.; Mann, S.; Davis, S.A.; et al. Nanoparticles can cause DNA damage across a cellular barrier. Nat. Nanotechnol. 2009, 4, 876–883. [Google Scholar] [CrossRef]
- Chen, J.; Li, S.; Luo, J.; Wang, R.; Ding, W. Enhancement of the antibacterial activity of silver nanoparticles against phytopathogenic bacterium Ralstonia solanacearum by stabilization. J. Nanomater. 2016, 2016, 7135852. [Google Scholar] [CrossRef]
- Cai, L.; Chen, J.; Liu, Z.; Wang, H.; Yang, H.; Ding, W. Magnesium Oxide Nanoparticles: Effective Agricultural Antibacterial Agent Against Ralstonia solanacearum. Front. Microbiol. 2018, 9, 790. [Google Scholar] [CrossRef] [PubMed]
- Chen, J.; Wu, L.; Lu, M.; Lu, S.; Li, Z.; Ding, W. Comparative Study on the Fungicidal Activity of Metallic MgO Nanoparticles and Macroscale MgO Against Soilborne Fungal Phytopathogens. Front. Microbiol. 2020, 11, 365. [Google Scholar] [CrossRef]
- Lopes, S.; Pinheiro, C.; Soares, A.M.; Loureiro, S. Joint toxicity prediction of nanoparticles and ionic counterparts: Simulating toxicity under a fate scenario. J. Hazard. Mater. 2016, 320, 1–9. [Google Scholar] [CrossRef] [PubMed]
- Thakur, N.; Ghosh, J.; Pandey, S.K.; Pabbathi, A.; Das, J. A comprehensive review on biosynthesis of magnesium oxide nanoparticles, and their antimicrobial, anticancer, antioxidant activities as well as toxicity study. Inorg. Chem. Commun. 2022, 146. [Google Scholar] [CrossRef]
- Wani, A.; Shah, M. A unique and profound effect of MgO and ZnO nanoparticles on some plant pathogenic fungi. J. Appl. Pharm. Sci. 2012, 2012, 40–44. [Google Scholar]
- Pavithra, S.; Mohana, B.; Mani, M.; Saranya, P.E.; Jayavel, R.; Prabu, D.; Kumaresan, S. Bioengineered 2D Ultrathin Sharp-Edged MgO Nanosheets Using Achyranthes aspera Leaf Extract for Antimicrobial Applications. J. Inorg. Organomet. Polym. Mater. 2020, 31, 1120–1133. [Google Scholar] [CrossRef]
- Podder, S.; Chanda, D.; Mukhopadhyay, A.K.; De, A.; Das, B.; Samanta, A.; Hardy, J.G.; Ghosh, C.K. Effect of Morphology and Concentration on Crossover between Antioxidant and Pro-oxidant Activity of MgO Nanostructures. Inorg. Chem. 2018, 57, 12727–12739. [Google Scholar] [CrossRef] [PubMed]
- Li, J.; Zhuang, S. Antibacterial activity of chitosan and its derivatives and their interaction mechanism with bacteria: Current state and perspectives. Eur. Polym. J. 2020, 138. [Google Scholar] [CrossRef]
- Güler, Ö.; Bağcı, N. A short review on mechanical properties of graphene reinforced metal matrix composites. J. Mater. Res. Technol. 2020, 9, 6808–6833. [Google Scholar] [CrossRef]
- Yamamoto, O.; Ohira, T.; Alvarez, K.; Fukuda, M. Antibacterial characteristics of CaCO3–MgO composites. Mater. Sci. Eng. B 2010, 173, 208–212. [Google Scholar] [CrossRef]
- Wang, Y.; Cen, C.; Chen, J.; Fu, L. MgO/carboxymethyl chitosan nanocomposite improves thermal stability, waterproof and antibacterial performance for food packaging. Carbohydr. Polym. 2020, 236, 116078. [Google Scholar] [CrossRef] [PubMed]
- Sabbagh, F.; Muhamad, I.I. Acrylamide-based hydrogel drug delivery systems: Release of Acyclovir from MgO nanocomposite hydrogel. J. Taiwan Inst. Chem. Eng. 2017, 72, 182–193. [Google Scholar] [CrossRef]
- Zhu, X.; Wu, D.; Wang, W.; Tan, F.; Wong, P.K.; Wang, X.; Qiu, X.; Qiao, X. Highly effective antibacterial activity and synergistic effect of Ag-MgO nanocomposite against Escherichia coli. J. Alloy. Compd. 2016, 684, 282–290. [Google Scholar] [CrossRef]

| No. | Green Source | Magnesium Source | Particle Size (nm) | Morphology | Ref. |
|---|---|---|---|---|---|
| 1 | Bauhinia purpurea leaf extract | Magnesium chloride | 10–11 | Nanoflakes | [72] |
| 2 | Prosopis farcta leaf extract | Magnesium nitrate | 30−40 | Nanowires | [73] |
| 3 | Pisonia alba leaf extract | Magnesium nitrate | <100 | Roughly spherical | [74] |
| 4 | Matricaria chamomilla L. extract | Magnesium nitrate | 18.2 | Disc-shape | [75] |
| 5 | Emblica officinalis fruits | Magnesium nitrate | 27 | Spherical | [76] |
| 6 | Limonia acidissima fruits | Magnesium nitrate | 4−8 | Different shapes (flower-shaped, spherical and flake- shaped) | [77] |
| 7 | Citrus aurantium fruit peels | Magnesium nitrate | 50−60 | Spherical | [78] |
| 8 | Annona squamosa seeds | Magnesium nitrate | 27 and 68 | Irregular | [79] |
| 9 | Banana peel | Magnesium nitrate | 15−20 | Nanopowder | [80] |
| 10 | Artemisia abrotanum herb extract | Magnesium nitrate | 10 | Spherical | [81] |
| 11 | Camellia-sinensis leaves extract | Magnesium nitrate | Up to 80 | NPs | [82] |
| 12 | Aloe barbadensis leaf latex extract | Magnesium nitrate | Liquid extract = 25−35, Solid extract = 39−60 | Spherical | [83] |
| 13 | Trachyspermum ammi leaf extract | Magnesium nitrate | 78.48 | Spherical | [84] |
| 14 | Hibiscus rosa sinensis leaf extract | Magnesium sulphate | 27.72 | NPs | [85] |
| 15 | Pterocarpus marsupium heartwood extract | Magnesium nitrate | 5−20 | Spherical | [86] |
Disclaimer/Publisher’s Note: The statements, opinions and data contained in all publications are solely those of the individual author(s) and contributor(s) and not of MDPI and/or the editor(s). MDPI and/or the editor(s) disclaim responsibility for any injury to people or property resulting from any ideas, methods, instructions or products referred to in the content. |
© 2023 by the authors. Licensee MDPI, Basel, Switzerland. This article is an open access article distributed under the terms and conditions of the Creative Commons Attribution (CC BY) license (https://creativecommons.org/licenses/by/4.0/).
Share and Cite
Ramezani Farani, M.; Farsadrooh, M.; Zare, I.; Gholami, A.; Akhavan, O. Green Synthesis of Magnesium Oxide Nanoparticles and Nanocomposites for Photocatalytic Antimicrobial, Antibiofilm and Antifungal Applications. Catalysts 2023, 13, 642. https://doi.org/10.3390/catal13040642
Ramezani Farani M, Farsadrooh M, Zare I, Gholami A, Akhavan O. Green Synthesis of Magnesium Oxide Nanoparticles and Nanocomposites for Photocatalytic Antimicrobial, Antibiofilm and Antifungal Applications. Catalysts. 2023; 13(4):642. https://doi.org/10.3390/catal13040642
Chicago/Turabian StyleRamezani Farani, Marzieh, Majid Farsadrooh, Iman Zare, Amir Gholami, and Omid Akhavan. 2023. "Green Synthesis of Magnesium Oxide Nanoparticles and Nanocomposites for Photocatalytic Antimicrobial, Antibiofilm and Antifungal Applications" Catalysts 13, no. 4: 642. https://doi.org/10.3390/catal13040642
APA StyleRamezani Farani, M., Farsadrooh, M., Zare, I., Gholami, A., & Akhavan, O. (2023). Green Synthesis of Magnesium Oxide Nanoparticles and Nanocomposites for Photocatalytic Antimicrobial, Antibiofilm and Antifungal Applications. Catalysts, 13(4), 642. https://doi.org/10.3390/catal13040642

